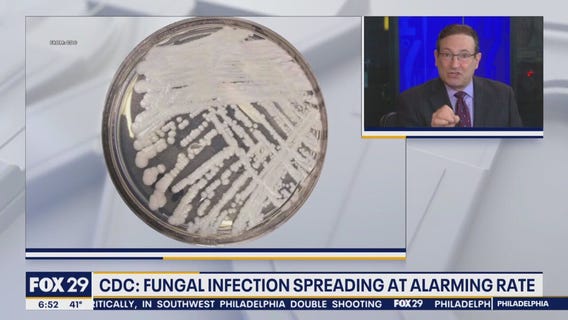
Health Watch: CDC warning of fungal infection spreading at 'alarming rate'

Health Watch: Malaria resurfacing in the US
Dr. Mike joins "Good Day Philadelphia" to discuss today's top health headlines, including Madonna's hospitalization and recent domestic malaria cases.
Passengers abroad missing sub face dangerous health conditions
Dr. Mike joins "Good Day Philadelphia" to discuss the dangerous health conditions passengers on the missing submersible on its way to the Titanic wreckage site face as time runs out.
Health Watch: New data shows using a gas stove is like living with a smoker
Dr. Mike joins "Good Day Philadelphia" with FOX 29's Alex Holley and Thomas Drayton to discuss today's top health headlines.
Autopsy finds Olympian Tori Bowie died from complications of childbirth
Dr. Mike joins "Good Day Philadelphia" to discuss today's top health headlines, including Tori Bowie's death caused by complications from childbirth.
Health Watch: Experts warn you shouldn't sleep naked during a heat wave
Experts are warning against sleeping naked during heat waves and moments of extreme heat. Dr. Mike joins "Good Day Philadelphia" to discuss.
Which masks should you wear outdoors with poor air quality?
Dr. Mike breaks down what types of particles can be found in wildfire smoke and what types of masks may offer protection.
Health Watch: Berberine gains momentum on social media for weight loss
Dr. Mike joins "Good Day Philadelphia" to discuss the social media momentum dietary supplement berberine has gained on social media.
Health Watch: Taking daily multivitamins can slow cognitive aging
Dr. Mike joins "Good Day Philadelphia" to discuss how cognitive aging can be slowed by taking multivitamins.
Research suggests Ozempic can help fight cancer
Dr. Mike explains new research that suggests Ozempic can help fight cancer.
FDA panel approves over the counter birth control pill
Dr. Mike joins "Good Day Philadelphia" to discuss the FDA advisory panels approval of over the counter birth control.
Doctors perform brain surgery on fetus in mother's womb
Dr. Mike Cirgliano joins "Good Day Philadelphia" to discuss today's top trending medical stories.
Health Watch: Cranberry juice can help women with a common illness
Dr. Mike joins Bill Anderson to discuss a health hack that can help women who suffer from urinary track infections.
Latest COVID-19 variant causing pink eye
Dr. Mike joins "Good Day Philadelphia" to discuss the latest COVID-19 variant, which is causing pink eye in patients.
Health Watch: Sexually transmitted diseases jumped by 7% in 2021, CDC says
Dr. Mike joins "Good Day Philadelphia" to discuss CDC data that shows a rise in sexually transmitted diseases in 2021.
Health Watch: Moderate drinking is not good for your health
Dr. Mike joins Alex and Mike on "Good Day Philadelphia" to discuss how moderate drinking is not good for your health.
Study finds blood tests can predict tumors years before they form
Dr. Mike joins "Good Day Philadelphia" to discuss today's top medical headlines.
Health Watch: CDC warning of fungal infection spreading at 'alarming rate'
Dr. Mike joins "Good Day Philadelphia" to discuss the CDC's warning about a fungal infection spreading at an "alarming rate."
Health Watch: Bird flu outbreak causing seal deaths
Dr. Mike joins Karen & Mike on "Good Day Philadelphia" to discuss seal deaths connected to bird flu.
Health Watch: FDA to review common over-the-counter medicines
The FDA is set to review common over-the-counter cold mediciation, including Sudafed. Dr. Mike joins "Good Day Philadelphia" to discuss.
Health Watch: Researhers confirm 5th person cured of HIV
Dr. Mike joins "Good Day Philadelphia" to disucss today's top health headlines.